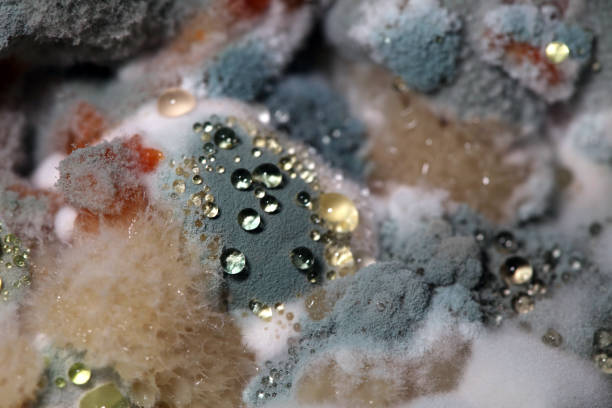

Суннат ва замонавий илм

Инсон танаси, унинг барча қисмлари ҳозирги кунга қадар ҳам охиригача ўрганилмаган ажойиб, мукаммал лойиҳа. Инсон танасининг тузилишини энг замонавий технологик давоми...
8958 16:01 / 26.11.2018

Ғарблик бир аёл мутлақо тузалмас, даҳшатли бир касалликка чалинди. Табиблар .рак, ndash саратон деб аталмиш бу дард қаршисида ожиз эдилар. Бечора аёлнинг яшашга давоми...
6483 15:04 / 20.11.2018

Аввал айтиб ўтилганидек, суннат барча тарафдан Қуръони Каримдан кейин, иккинчи ўринда туради. Балоғат ва фасоҳатда ҳам, шаръий ҳукмларда ҳам, жумладан, илмий давоми...
4965 15:09 / 16.11.2018

Думғаза мўъжизасиҚуръони карим ва Пайғамбаримиз Муҳаммад соллаллоҳу алайҳи васалламдан ривоят қилинган ҳадисларда инсон вужудидаги, табиатдаги жуда кўп давоми...
12807 11:02 / 12.11.2018
Бу мақоламиздаги тавсиялар баъзи ўқувчиларимизга илк ўқишда оддийгина бўлиб кўриниши мумкин. Лекин улар ўтган 1400 йилга ҳаёлий саёҳат қилсалар, ақлларини лол давоми...
5979 18:08 / 08.11.2018

Кунлар ўтган сайин Қуръони каримга ҳайронлик ортиб бормоқда. Олмониялик Ҳенри Миллер бир мақоласида шу нарсаларни ёзади quotҚуръонни ўрганган ғайри муслимларни давоми...
4667 21:03 / 04.11.2018

Маълумки, тиббиётда шахсий гигиена деб аталувчи тушунча мавжуд. Шахсий гигиена ҳар бир кишининг ўзига ва ёшига боғлиқ бўлиб, ақлий ва жисмоний меҳнатни тўғри давоми...
6941 11:59 / 29.10.2018

Пайғамбаримиз соллаллоҳу алайҳи васалламдан, у киши айрим саҳобаларнинг қорни билан ётган ҳолда ухлаётганини кўриб, уларнинг оёқларини қимирлатиб шундай давоми...
9913 12:30 / 25.10.2018

Зайд ибн Холид розияллоҳу анҳудан ривоят қилади Набий соллаллоҳу алайҳи васаллам Агар умматимга машаққат бўлишини ўйламаганимда, албатта, уларни ҳар намоздан давоми...
6547 12:35 / 22.10.2018

Германияда бир мусулмон инсон фарзанд кўради. Суннатга мувофиқ иш кўришни ният қилган оила бошлиғи еттинчи куни боланинг сочини олади ва соч оғирлигида олтин давоми...
5217 11:28 / 18.10.2018

quotЙўқ Қасамки, агар у бу йўлидан қайтмаса, албатта, Биз уни пешонасидан тутамиз. Ўша ёлғончи, адашган гуноҳкор пешонани тутиб жаҳаннамга отурмизquot Алақ сураси, давоми...
5007 18:02 / 15.10.2018

Эрта туриш. Набий алайҳиссаломнинг эрта туриш одатлари бўлган, тонгги азон вақтида уйғонганлар. Албатта, эрта туриш кун бўйи инсонга тетиклик ҳамда ишчанлик давоми...
4952 17:02 / 12.10.2018
Видеолар
365 18:43 / 23 февраль
311 21:10 / 20 февраль
Аудиолар
232737 11:58 / 10.10.2018
252878 11:56 / 10.10.2018
«Ҳилол» журнали






























